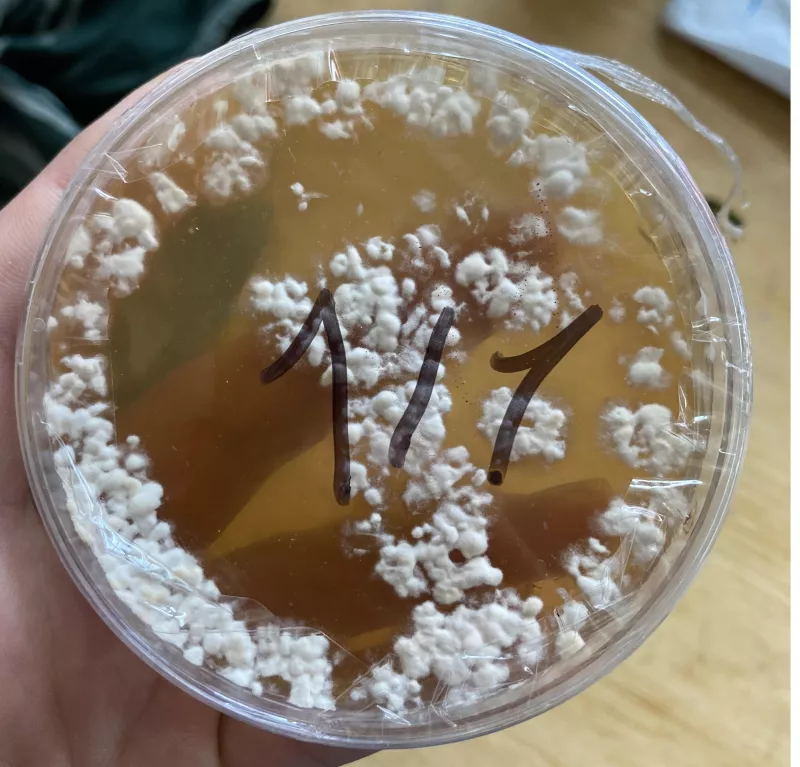
/forum/uploads/images/1762/agar.webp

[ Culture ]
Culture liquide après 8 mois au frigo
Publié par Alduin Balek,
79 vues, 2 réponses
#1
- Alduin Balek

Nouveau membre - Hier à 14:19
Salut à tous!
Il y a 8 mois a peu près, j'ai acheté tout le matériel nécessaire pour me lancer dans une culture autonome, après avoir récupéré les spores de mckeenai poussés dans une box Z*******, j'ai inoculé des cultures liquides en suivant tout les tutos de SillyCone sur le forum.
Malheureusement j'ai pas eu la foi de me lancer dans la suite de la culture directement et j'ai voulu tout mettre en pose.
J'aimerais reprendre la ou je me suis arrêté mais j'ai peur de gacher mon grain et mon temps en utilisant mes cultures, probablement contaminées.
J'aimerais donc que vous m'aidiez, si vous le voulez bien, a savoir si mes cultures sont toujours bonnes, sachant qu'elles ont passé 8 mois au frigo
voilà les photos:
les deux cultures avant d'être secouées:
Celle de gauche secouée:

Celle de droite secouée:

Voilà, les petits points noirs sont présents depuis l'inoculation, je suis partis du principe que c'était des spores mais aujourd'hui ils me font quand meme douter
Voici un agar + antibio que j'avais fais avec une des culture, malheureusement impossible de me rappeler laquelle :

Voilà j'espère que les photos suffiront même si je me doute que c'est compliqué a déterminer hehe
Bonne journée!
Il y a 8 mois a peu près, j'ai acheté tout le matériel nécessaire pour me lancer dans une culture autonome, après avoir récupéré les spores de mckeenai poussés dans une box Z*******, j'ai inoculé des cultures liquides en suivant tout les tutos de SillyCone sur le forum.
Malheureusement j'ai pas eu la foi de me lancer dans la suite de la culture directement et j'ai voulu tout mettre en pose.
J'aimerais reprendre la ou je me suis arrêté mais j'ai peur de gacher mon grain et mon temps en utilisant mes cultures, probablement contaminées.
J'aimerais donc que vous m'aidiez, si vous le voulez bien, a savoir si mes cultures sont toujours bonnes, sachant qu'elles ont passé 8 mois au frigo
voilà les photos:
les deux cultures avant d'être secouées:

Celle de gauche secouée:


Celle de droite secouée:


Voilà, les petits points noirs sont présents depuis l'inoculation, je suis partis du principe que c'était des spores mais aujourd'hui ils me font quand meme douter
Voici un agar + antibio que j'avais fais avec une des culture, malheureusement impossible de me rappeler laquelle :
Voilà j'espère que les photos suffiront même si je me doute que c'est compliqué a déterminer hehe
Bonne journée!
Hors ligne
#2

- Krazy-Damdam

Nouveau Psycho
- Hier à 18:16
Humm tu as pas un couche blanche sur le dessus de tes cultures liquides au bout d'un moment le mycelium est censé chercher de l'air? Des points noirs c'est pas rassurant x). Dans le doute je ferai des tests sur boite de petri mais ça a pas l'air d'avoir de grosses contamination.
Hors ligne
#3
- Alduin Balek

Nouveau membre - Aujourd'hui à 13:02
j'ai un peu peur de faire des tests sur pétri, en SAB il me semble qu'ouvrir grand une boite c'est de gros risques de contamination
Je pense repartir de zéro avec une seringue de spores achetée chez un producteur comme ça rien besoin d'ouvrir je ferais tout avec les ports d'injection
Merci quand même pour ta réponse, c'est cool :)
Je pense repartir de zéro avec une seringue de spores achetée chez un producteur comme ça rien besoin d'ouvrir je ferais tout avec les ports d'injection
Merci quand même pour ta réponse, c'est cool :)
Hors ligne
Sujets similaires dans les forums, psychowiki et QuizzZ

3
[ Stockage & conservation ]
Truffes fraîches sous vides conservées au frigo pendant 4 mois : périmées ou pas ?
1
[ Culture ]
Question sur la culture liquide

Psychoactif » Forums » Enthéogènes » Psilocybe - Champignon magique - Truffe
» [ Culture ] Culture liquide après 8 mois au frigo
» [ Culture ] Culture liquide après 8 mois au frigo
Psychoactif
Psychoactif est une communauté dédiée à l'information, l'entraide, l'échange d'expériences et la construction de savoirs sur les drogues, dans une démarche de réduction des risques. Droit d'auteur : les textes de Psychoactif de https://www.psychoactif.org sont sous licence CC by NC SA 3.0 sauf mention contraire.
Affichage Bureau - A propos de Psychoactif - Politique de confidentialité - CGU - Contact -
 0, 2610 vues, dernier message :
0, 2610 vues, dernier message :  Soutenez PsychoACTIF
Soutenez PsychoACTIF